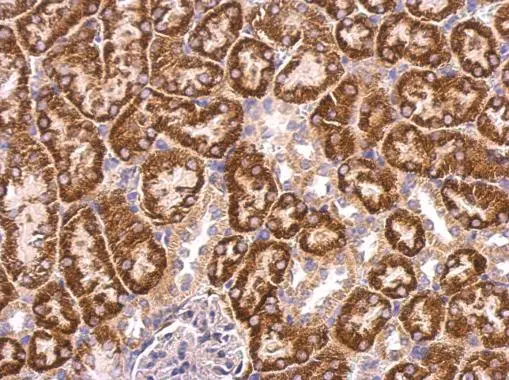
ABAT antibody detects ABAT protein at mitochondria on mouse kidney by immunohistochemical analysis. Sample: Paraffin-embedded mouse kidney. ABAT antibody (GTX100479) dilution: 1:500. 
 Antigen Retrieval: Trilogy? (EDTA based, pH 8.0) buffer, 15min

ABAT antibody detects ABAT protein at cytoplasm in rat brain by immunohistochemical analysis. Sample: Paraffin-embedded rat brain. ABAT antibody (GTX100479) diluted at 1:500.
Antigen Retrieval: Citrate buffer, pH 6.0, 15 min
ABAT antibody
GTX100479
ApplicationsImmunoFluorescence, Western Blot, ImmunoCytoChemistry, ImmunoHistoChemistry, ImmunoHistoChemistry Frozen, ImmunoHistoChemistry Paraffin
Product group Antibodies
ReactivityHuman, Mouse, Rat
TargetABAT
Overview
- SupplierGeneTex
- Product NameABAT antibody
- Delivery Days Customer9
- Application Supplier NoteWB: 1:500-1:10000. ICC/IF: 1:100-1:1000. IHC-P: 1:100-1:1000. IHC-Fr: 1:100-1:1000. *Optimal dilutions/concentrations should be determined by the researcher.Not tested in other applications.
- ApplicationsImmunoFluorescence, Western Blot, ImmunoCytoChemistry, ImmunoHistoChemistry, ImmunoHistoChemistry Frozen, ImmunoHistoChemistry Paraffin
- CertificationResearch Use Only
- ClonalityPolyclonal
- Concentration1 mg/ml
- ConjugateUnconjugated
- Gene ID18
- Target nameABAT
- Target description4-aminobutyrate aminotransferase
- Target synonymsGABA-AT, GABAT, NPD009, 4-aminobutyrate aminotransferase, mitochondrial, (S)-3-amino-2-methylpropionate transaminase, 4-aminobutyrate transaminase, GABA aminotransferase, GABA transaminase, GABA transferase, gamma-amino-N-butyrate transaminase, gamma-aminobutyrate aminotransferase
- HostRabbit
- IsotypeIgG
- Protein IDP80404
- Protein Name4-aminobutyrate aminotransferase, mitochondrial
- Scientific Description4-aminobutyrate aminotransferase (ABAT) is responsible for catabolism of gamma-aminobutyric acid (GABA), an important, mostly inhibitory neurotransmitter in the central nervous system, into succinic semialdehyde. The active enzyme is a homodimer of 50-kD subunits complexed to pyridoxal-5-phosphate. The protein sequence is over 95% similar to the pig protein. GABA is estimated to be present in nearly one-third of human synapses. ABAT in liver and brain is controlled by 2 codominant alleles with a frequency in a Caucasian population of 0.56 and 0.44. The ABAT deficiency phenotype includes psychomotor retardation, hypotonia, hyperreflexia, lethargy, refractory seizures, and EEG abnormalities. Multiple alternatively spliced transcript variants encoding the same protein isoform have been found for this gene. [provided by RefSeq]
- ReactivityHuman, Mouse, Rat
- Storage Instruction-20°C or -80°C,2°C to 8°C
- UNSPSC12352203

![ABAT antibody detects ABAT protein expression by immunohistochemical analysis. Sample: Frozen sectioned adult mouse retina. Green: ABAT protein stained by ABAT antibody (GTX100479) diluted at 1:250. Red: beta Tubulin 3/ TUJ1, stained by beta Tubulin 3/ TUJ1 antibody [GT11710] (GTX631836) diluted at 1:250. Blue: Fluoroshield with DAPI (GTX30920). ABAT antibody detects ABAT protein expression by immunohistochemical analysis. Sample: Frozen sectioned adult mouse retina. Green: ABAT protein stained by ABAT antibody (GTX100479) diluted at 1:250. Red: beta Tubulin 3/ TUJ1, stained by beta Tubulin 3/ TUJ1 antibody [GT11710] (GTX631836) diluted at 1:250. Blue: Fluoroshield with DAPI (GTX30920).](https://www.genetex.com/upload/website/prouct_img/normal/GTX100479/GTX100479_39456_20170214_IHC-Fr_w_23060100_193.webp)


![ABAT antibody detects ABAT protein expression by immunohistochemical analysis. Sample: Frozen sectioned E13.5 Rat brain. Green: ABAT protein stained by ABAT antibody (GTX100479) diluted at 1:250. Red: beta Tubulin 3/ TUJ1, a mature neuron marker, stained by beta Tubulin 3/ TUJ1 antibody [GT11710] (GTX631836) diluted at 1:500. Blue: Fluoroshield with DAPI (GTX30920). ABAT antibody detects ABAT protein expression by immunohistochemical analysis. Sample: Frozen sectioned E13.5 Rat brain. Green: ABAT protein stained by ABAT antibody (GTX100479) diluted at 1:250. Red: beta Tubulin 3/ TUJ1, a mature neuron marker, stained by beta Tubulin 3/ TUJ1 antibody [GT11710] (GTX631836) diluted at 1:500. Blue: Fluoroshield with DAPI (GTX30920).](https://www.genetex.com/upload/website/prouct_img/normal/GTX100479/GTX100479_39456_20161005_IHC-Fr_R_w_23060100_909.webp)







